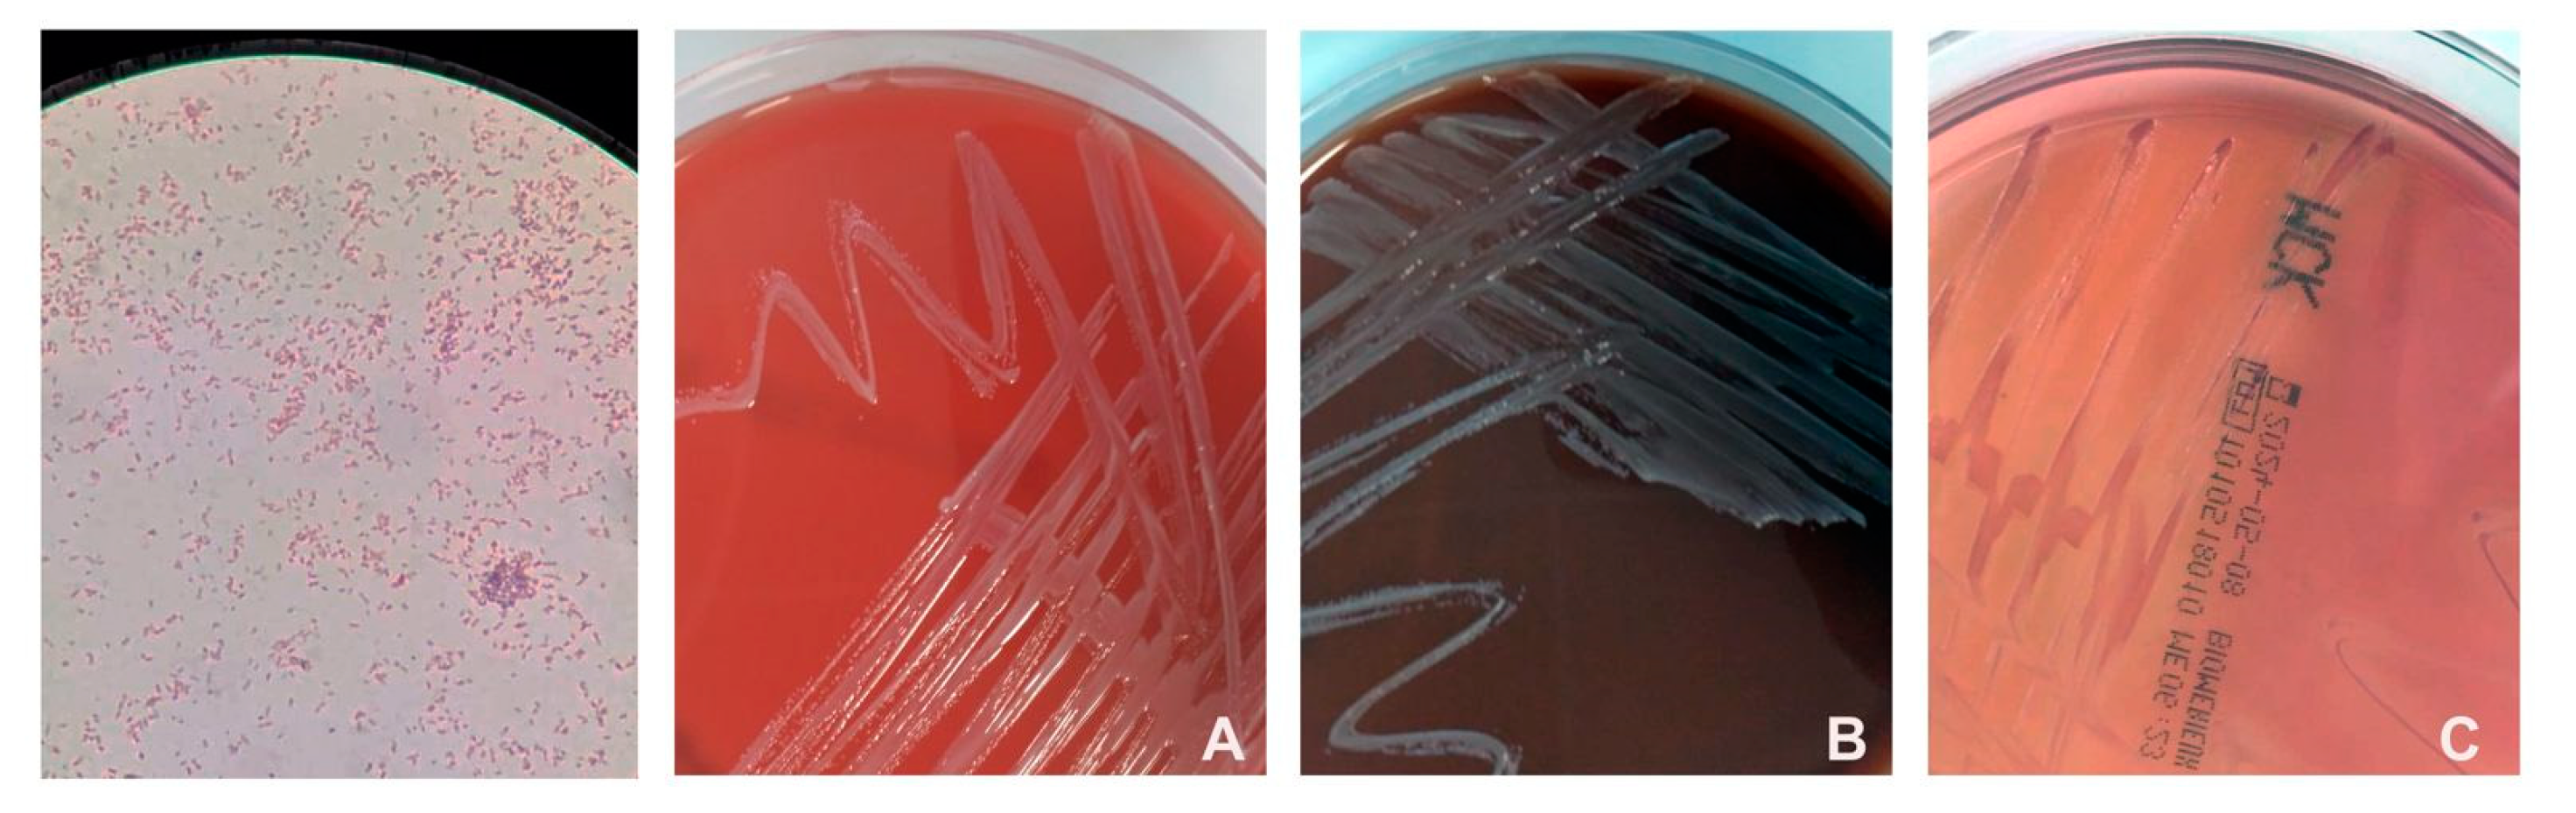
Hygiene 04 00012 g001

Ralstonia insidiosa Bacteremia in Patients with Solid Cancer Treated by Means of a Central Venous Catheter
Abstract
1. Introduction
2. Materials and Methods
3. Results
4. Discussion
Author Contributions
Funding
Institutional Review Board Statement
Informed Consent Statement
Data Availability Statement
Acknowledgments
Conflicts of Interest
References
- Ryan, M.P.; Adley, C.C. Ralstonia spp.: Emerging global opportunistic pathogens. Eur. J. Clin. Microbiol. Infect. Dis. 2014, 33, 291–304. [Google Scholar] [CrossRef] [PubMed]
- Eucast: Clinical Breakpoints and Dosing of Antibiotics. Available online: https://www.eucast.org/clinical_breakpoints (accessed on 26 November 2022).
- Ramani, V.K.; Ganesha Dv Sarathy, V.; Bhattacharjee, S.; Ganeshan, S.; Naik, R. Outbreak of Ralstonia mannitolilytica Infection at a Tertiary Care Oncology Center in South India: A Case Series. Asian Pac. J. Cancer Biol. 2021, 6, 87–92. [Google Scholar] [CrossRef]
- Nosocomial Ralstonia pickettii Colonization Associated with Intrinsically Contaminated Saline Solution—Los Angeles, California, 1998. Available online: https://www.cdc.gov/mmwr/preview/mmwrhtml/00052013.htm (accessed on 26 November 2022).
- Gröbner, S.; Heeg, P.; Autenrieth, I.B.; Schulte, B. Monoclonal outbreak of catheter-related bacteraemia by Ralstonia mannitolilytica on two haemato-oncology wards. J. Infect. 2007, 55, 539–544. [Google Scholar] [CrossRef] [PubMed]
- Marroni, M.; Pasticci, M.B.; Pantosti, A.; Colozza, M.A.; Stagni, G.; Tonato, M. Outbreak of Infusion-Related Septicemia by Ralstonia pickettii in the Oncology Department. Tumori 2003, 89, 575–576. [Google Scholar] [CrossRef] [PubMed]
- Lucarelli, C.; Di Domenico, E.G.; Toma, L.; Bracco, D.; Prignano, G.; Fortunati, M.; Pelagalli, L.; Ensoli, F.; Pezzotti, P.; García-Fernández, A.; et al. Ralstonia mannitolilytica infections in an oncologic day ward: Description of a cluster among high-risk patients. Antimicrob. Resist. Infect. Control 2017, 6, 20. [Google Scholar] [CrossRef] [PubMed]
- Mikulska, M.; Durando, P.; Pia Molinari, M.; Alberti, M.; Del Bono, V.; Dominietto, A.; Raiola, A.M.; van Lint, M.T.; Bregante, S.; Orengo, G.; et al. Outbreak of Ralstonia pickettii bacteraemia in patients with haematological malignancies and haematopoietic stem cell transplant recipients. J. Hosp. Infect. 2009, 72, 187–188. [Google Scholar] [CrossRef] [PubMed]
- Van der beek, D.; Magerman, K.; Bries, G.; Mewis, A.; Declercq, P.E.; Peeters, V.; Rummens, J.L.; Raymaekers, M.; Cartuyvels, R. Infection with Ralstonia insidiosa in two patients. Clin. Microbiol. Newsl. 2005, 27, 159–161. [Google Scholar] [CrossRef]
- Fang, Q.; Feng, Y.; Feng, P.; Wang, X.; Zong, Z. Nosocomial bloodstream infection and the emerging carbapenem-resistant pathogen Ralstonia insidiosa. BMC Infect. Dis. 2019, 19, 334. [Google Scholar] [CrossRef]
- Akduman Alaşehir, E.; Öngen İpek, B.; Thomas, D.T.; Sitar, M.E.; Erener Ercan, T. Ralstonia insidiosa neonatal sepsis: A case report and review of the literature. Pediatr. Infect. Dis. J. 2020, 15, 148–151. [Google Scholar] [CrossRef]
- Aranas, D.R.; Demot, B.A.; Cajulao, T.P.T. Outbreak of Ralstonia bacteraemia among chronic kidney disease patients in a haemodialysis unit in the Philippines. West. Pac. Surveill. Response J. 2022, 13, 1–6. [Google Scholar] [CrossRef] [PubMed]
- Tüzemen, N.Ü.; Önal, U.; Kazak, E.; Tezgeç, N.; Eren, H.; Şimşek, H.; Bakkaloğlu, Z.; Ünaldı, Ö.; Çelebi, S.; Yılmaz, E.; et al. An outbreak of Ralstonia insidiosa bloodstream infections caused by contaminated heparinized syringes. J. Infect. Chemother. 2022, 28, 1387–1392. [Google Scholar] [CrossRef] [PubMed]
- Marrie, T.J.; Costerton, J.W. Prolonged Survival of Serratia Marcescens in Chlorhexidine. Appl. Environ. Microbiol. 1981, 42, 1093–1102. [Google Scholar] [CrossRef] [PubMed]
- Brooks, S.E.; Walczak, M.A.; Hameed, R.; Coonan, P. Chlorhexidine Resistance in Antibiotic-Resistant Bacteria Isolated from the Surfaces of Dispensers of Soap Containing Chlorhexidine. Infect. Control Hosp. Epidemiol. 2002, 23, 692–695. [Google Scholar] [CrossRef] [PubMed]
- Mellmann, A.; Cloud, J.; Maier, T.; Keckevoet, U.; Ramminger, I.; Iwen, P.; Dunn, J.; Hall, G.; Wilson, D.; LaSala, P.; et al. Evaluation of matrix-assisted laser desorption ionization-time-of-flight mass spectrometry in comparison to 16S rRNA gene sequencing for species identification of nonfermenting bacteria. J. Clin. Microbiol. 2008, 46, 1946–1954. [Google Scholar] [CrossRef] [PubMed]
- Degand, N.; Carbonnelle, E.; Dauphin, B.; Beretti, J.L.; Le Bourgeois, M.; Sermet-Gaudelus, I.; Segonds, C.; Berche, P.; Nassif, X.; Ferroni, A.; et al. Matrix-assisted laser desorption ionization-time of flight mass spectrometry for identification of nonfermenting gram-negative bacilli isolated from cystic fibrosis patients. J. Clin. Microbiol. 2008, 46, 3361–3367. [Google Scholar] [CrossRef] [PubMed]
- Nurjadi, D.; Boutin, S.; Schmidt, K.; Ahmels, M.; Hasche, D. Identification and elimination of the clinically relevant multi-resistant environmental bacteria Ralstonia insidiosa in Primary Cell Culture. Microorganisms 2020, 8, 1599. [Google Scholar] [CrossRef] [PubMed]
- Mennim, P.; Coyle, C.F.; Taylor, J.D. Venous air embolism associated with removal of central venous catheter. BMJ 1992, 305, 171–172. [Google Scholar] [CrossRef] [PubMed]
- Vinson, D.R.; Ballard, D.W.; Hance, L.G.; Hung, Y.; Rauchwerger, A.S.; Reed, M.E.; Kene, M.V.; Chettipally, U.K.; Elms, A.R.; Mark, D.G.; et al. Bleeding complications of central venous catheterization in septic patients with abnormal hemostasis. Am. J. Emerg. Med. 2014, 32, 737–742. [Google Scholar] [CrossRef] [PubMed]
| Case | Sex | Age | Cancer Type | Ongoing Anti-Cancer Treatment | Time from PAC Placement to Bacteremia (Months) | Date of First Positive Blood Culture | Associated Symptoms | MALDI-TOF MS Identification (% Confidence Value) | Antibiotic Treatment | Recurrence of Bacteremia with Use of PAC | Outcomeome |
|---|---|---|---|---|---|---|---|---|---|---|---|
| 1 | F | 50 | Breast cancer | Trastuzumab-paclitaxel | 4 | 14 January 2022: blood drawn from peripheral vein and PAC | Shaking chills, rash, scapular arthralgia for 3 days after infusion | Ralstonia insidiosa (99.9) | Ciprofloxacin; lock-therapy with piperacillin/ tazobactam | Yes | Symptoms: no recurrence after lock therapy; Bacteremia: resolved only after PAC removal |
| 2 | F | 53 | Breast cancer | Trastuzumab | 12 | 21 January 2022: blood drawn from peripheral vein and PAC | Fever (40 °C), headache, arthralgia only during infusion | Ralstonia insidiosa (99.9) | Levofloxacin | Yes | Symptoms: no recurrence after antibiotic therapy; Bacteremia: resolved only after PAC removal |
| 3 | F | 54 | Breast cancer | Trastuzumab-paclitaxel | 4 | 15 February 2022: blood drawn from PAC | Fever (38 °C), chills only during infusion | Ralstonia insidiosa (99.9) | Lock-therapy with piperacillin/ tazobactam | No | Symptoms and bacteremia resolved |
| 4 | F | 53 | Breast cancer | Paclitaxel | 3 | 17 February 2022: blood drawn from peripheral vein and PAC | Fever (38 °C) and shaking chills only during infusion | Ralstonia insidiosa (99.9) | Ciprofloxacin | No | Recovered |
| 5 | F | 68 | Breast cancer | Trastuzumab-pertuzumab | 46 | 4 March 2022: blood drawn from peripheral vein and PAC | Shaking chills and malaise on the day of infusion | Ralstonia insidiosa (99.9) | Lock-therapy with piperacillin/ tazobactam | No | Recovered |
| 6 | F | 68 | Breast cancer | Trastuzumab-pertuzumab | 21 | 9 March 2022: blood drawn from PAC | Shaking chills and malaise on the day of infusion | Ralstonia insidiosa (99.9) | Lock-therapy with piperacillin/ tazobactam | No | Recovered |
| 7 | M | 76 | Urothelial carcinoma | Pembrolizumab | 30 | 9 March 2022 Blood drawn from PAC | Shaking chills and malaise only during infusion | Ralstonia insidiosa (99.9) | Lock-therapy with piperacillin/ tazobactam | No | Recovered |
Disclaimer/Publisher’s Note: The statements, opinions and data contained in all publications are solely those of the individual author(s) and contributor(s) and not of MDPI and/or the editor(s). MDPI and/or the editor(s) disclaim responsibility for any injury to people or property resulting from any ideas, methods, instructions or products referred to in the content. |
© 2024 by the authors. Licensee MDPI, Basel, Switzerland. This article is an open access article distributed under the terms and conditions of the Creative Commons Attribution (CC BY) license (https://creativecommons.org/licenses/by/4.0/).
Share and Cite
Ruggieri, L.; Ridolfo, A.L.; Rimoldi, S.G.; Cona, M.S.; Dalu, D.; Olivieri, P.; Rizzardini, G.; Antinori, S.; Gambaro, A.; Ferrario, S.; et al. Ralstonia insidiosa Bacteremia in Patients with Solid Cancer Treated by Means of a Central Venous Catheter. Hygiene 2024, 4, 157-163. https://doi.org/10.3390/hygiene4020012
Ruggieri L, Ridolfo AL, Rimoldi SG, Cona MS, Dalu D, Olivieri P, Rizzardini G, Antinori S, Gambaro A, Ferrario S, et al. Ralstonia insidiosa Bacteremia in Patients with Solid Cancer Treated by Means of a Central Venous Catheter. Hygiene. 2024; 4(2):157-163. https://doi.org/10.3390/hygiene4020012
Chicago/Turabian StyleRuggieri, Lorenzo, Anna Lisa Ridolfo, Sara Giordana Rimoldi, Maria Silvia Cona, Davide Dalu, Pietro Olivieri, Giuliano Rizzardini, Spinello Antinori, Anna Gambaro, Sabrina Ferrario, and et al. 2024. "Ralstonia insidiosa Bacteremia in Patients with Solid Cancer Treated by Means of a Central Venous Catheter" Hygiene 4, no. 2: 157-163. https://doi.org/10.3390/hygiene4020012
APA StyleRuggieri, L., Ridolfo, A. L., Rimoldi, S. G., Cona, M. S., Dalu, D., Olivieri, P., Rizzardini, G., Antinori, S., Gambaro, A., Ferrario, S., Fasola, C., Antista, M., Rea, C. G., & La Verde, N. (2024). Ralstonia insidiosa Bacteremia in Patients with Solid Cancer Treated by Means of a Central Venous Catheter. Hygiene, 4(2), 157-163. https://doi.org/10.3390/hygiene4020012

